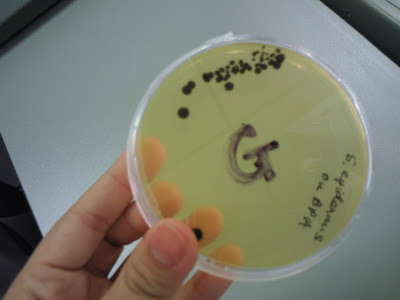

Have been long since my last post?, i think,LOL!!!!
Just a brief posting of my week...
Monday
-went for Karyaking trail.Tat's tiring.
-the team only need 20 girls and 20 guys!but! they had 60++ recruits for guys,16 for girls!HAHAHAH!!!!so obviously, all girls were accepted!
so, when i said, yes,
-i got SELECTED,was actually
-LYING!
There's nothing good in me tat they "selected" me, is they had
-NO CHOICE!
-BO BIAN!
-cos already not enough girls le!
HAHAHAHA...
-Met a girl named Yan Ling too!
TOTALLY same spelling.
-just tat her surname is Lim, mine is How!
ahhahha!!!
-knw how they address both of us?
-she's YAN. and
-i'm LING.
-knw who they referred when they call either YAN or LING.
LOL right!
hahahaha!!!!
-DIED FLAT when reached home.
Tuesday
-nothing much la...
-usual Lectures and tutorial.
-just project PROJect and more PROJECT!!!!
hahahaha!!!!!
- release at 2!
-GOOD DAY right? can go home early.
but then hor!
-met Shirlee. and
-i was told tat she wanna meet Siew Yin up for a small talk during her 2 hrs break.
-Well, initailly dnt wanna go.
-but was pulled by them
ahhahaha!!!
-SINFUL!
-I had my lunch at 11am! the Yong Tao Fu( dnt knw is it like tat spelled.lol)
knw wat!
-tempted to eat Dory fish at Mensa, when met up with tat 2 ladies!
LOLS!!!!!
-THEY LA!!!!lols!
-but was interesting to sit there gossiping than
-going library alone to find books.
-though, after the chat, was in the library to do some research la...
-end of my tuesday.
Wednesday
- Research RESEarch and still RESEARCH!
after that,
-Project PROJect and more PROJECT!
-lesson by lesson.
-end of my day.
and the
-last lesson of the day was
-CSAS(communication skills)
lol!!!!
-SO BORING! dnt knw wat teacher is talking!
-_-!!!!
-DIE for my project regarding tat subject.haix.
EH!!!!
-nono!
-not end of day yet!
-cos i still had to accompany Zhi Yuan to Triathlon "trial"
-It's a talk actually.
-start at 6 Pm! but now wat,
-talk until 8 Pm still haven finish.
I already
-no interest in joining tat already and he's super hungry!
-somemore he told me tat he only likes to SWIM.
piang eh!
blur him!
-TP got swimming de CCA ma!
-dared to tell me he DONT KNOW!!!!AIYO!
so both of us
-decided not to watse our time there and
-left early.
-I felt tat we are loser man!
-REAL LOSER!
-everyone listen to the cough words so
-ATTENTIVELY!
-only we kept
-fidgeting!
until one senior asked if we got to go,we said
-YES!
then he said just go off lor...
-we 2 chiong out!
-GOSH man!
-SO MALU!!!!! =(
-senior knw my name!
-cos my name too common!
-one of the team members named Yan Ling too!
I dont wanna named my daughter Yan Ling, i tell u.
LOL!!!
cos! I REALLY KNOW ALOT OF YAN LING!!!
-be it YAN or YEN,
-LING or LIN.
-Pronunciation still the same!
Thursday
-which is TODAY!!!! =))
-reached school at 8.15Am and
-my lesson start at 9Am!
knw why?
-wanna print my Pre-lab assignment but!
-com lab not open till 9Am!
-printing shop not open by 8.30Am!
-when it's open, too many people! -_-!!!!!!!!!!!!
ARGH!
-lucky, Lab teacher said not suppose to hand in today.
-hand in next Mon!
phew...
-cos she gave us too little time to complete it le.
-received on tues? ytd? then
-gonna hand in today-_-!!!!
Escherichia coli

 Bacillus cereus
Bacillus cereus
 Listeria monocytogenes
Listeria monocytogenes Vinrio parahaemolyticus
Vinrio parahaemolyticus
WHERE'S MY "F" AGAR SAMPLE!?!!!! =(
Staphylococcus epidermidis Saccharomyces cerevisiae
Saccharomyces cerevisiae
 Aspergillus niger
Aspergillus niger Salmonella enteritidis
Salmonella enteritidis
Just had 3 hours Lab doing those samples and we are
FREEEEEEEEEE!

so ZiTing and Sze Han decided to celebrate my birthday in ADVANCE!
super advance right?
HAAHAHA!!!!
nvm!
it's FUN with them around =)
Stupid me!
went to internet and check which is the nearest Jack's Place.
was stated tat there's one in Century Sqaure!
i THOUGHT i knw where.
u knw what?!!!!!
tat's not Jack's Place!
it's Billy Bombers..
-_-
so we " AIYA! anything la"
LOL!!!
we never try before anyway.
and think it's too early or wat?
the whole Restaurant only occupied US!
US! the THREE LADIES, not THREE blind mices ar!
AHAHAHAHHA!!!!
WOOTT~!!!!!!!!!!!!
I WAS SUPER HAPPY I TELL U!!!!
HAHAHAHAHAHA!!!!
The mushroom soup was WOW! WOOOT! DELECTABLE man!
HAHA!!!!
i cant resist it one! like SERIOUSLY!
llols.!!!
and i changed my standard drink(coke or sprite) to STRAWBERRY MILKSHAKE!
weet~!!!!!!
nice nice!!!!

 THIS IS VERY NOT GLAM!!!! ;O
THIS IS VERY NOT GLAM!!!! ;O 

GIVE ME MY MILKSHAKE!!!!
SO FAR FROM ME =(

I'm DRINKING IT! =)

KNOW WAT I'M DOING -_-
was telling Sze Han what we learnt. likw strawberry flavour consisted of how many hundred insects! -_-
She caught my stupid expression which i had no idea i did tat while talking.
LOL!!!!
I'M LOV'IN IT!!!
WOO WOO AH, WOO WOO AH!!!
MILKSHAKE MILKSHAKE WOSH WOSH,
MILKSHAKE MILKSHAKE WOSH!
hahahaahha!!!
My main course was Gilled Chicken with potato salad!
not bad.. the source was THUMB UP!

still love my milkshake though!
whenever i drank it, i will FLY!
SUPER HIGH AND HAPPY one sia!
HAHAHHA!


can u spot ZITING?

TATA> lol!

They surprised me by givingg me an ice-cream brownie cake!lol.
I was really surprised.

cos I din think so much, thought just a lunch celebration. somemore it's nt my actual day.
LOL!
THANK YOU GIRLS~!!!!!!!!!!!


My RETARD reaction again!
wanna take out the candle but the candle "holder?" stuck there!
-_-!!!
Went window shopping
GILRS just love to play ard!
GREAT TO BE WITH MY GIRLFRIENDS!

They very cute right.Lol!
 Sze Han~!
Sze Han~!
 ZiTing
ZiTing Do i look like
凤飞飞(Feng FeiFei)?
OR
more like
ba. ba la ba
ba. ba la ba
ba ba la...
...
THE WITCH!
Lol!!
 ZiTing
ZiTing,
Yan Ling,
Sze Han <3>


 NEVER APART =)
NEVER APART =)REALLY THANKS siol! =)
MUACK!
reached home ard evening time
and then
online and stuff..
then went jogging with my brother.
Followed him to try out his new route of running 10km.
from my block, (punggol) all the way to koven mrt station and back.
2 ways directions! =)
felt so shiok! tat i've completed it, 10 KM sia!
according to my brother la.
he mapped his route online and think it's ard there bahx..
HAHAHA!!!
He commented he din sweat at all! -_-
his muscles not aching.!
-_-
COS i ran too slowly la!
super slowly!
HAHAHAHA!!!!
i jogged as if i'm walking!
used
1 HR 23 MIN!
VERY VERY SLOW RIGHT?!!!!
LOLS.!
my small toes so pain =(
and YES!
my WHOLE legs are super pain now!= (
lols.. nvm...
just thought of completing 10 KM,
made me so woot~!
ABCDEFG
stand for
A Boy Can Do Everything For a Girl.
GFEDCBA
stand for
Girl Forgets Everything Done and Catches new Boy Again!
LOLS! i think it's quite true ar?
hahahahah!!!! girls may tend to take things for granted! :x
HUMAN WheelBarrow
Ytd was very happening yo!
TP had a Wheelbarrow challenge!
GUINNESS WORLD RECORD !!!!though i dnt knw if our school got break any record. cos it's too noisy to listen to the results.

LOL!!!!!

By right went there to help out in organising the students. but it was really in a mess..!!!!
NO COMMUNICATION!!!!
we dnt knw wat to do,
just stood there and like do nth?
TSK!
but nvm, i did get a chance to experience it..
I partnered MaoPei to go for the challenge.

LOL!!!!!
and i'm the one crawling!
GOSH man!
I have no energy cos i kept laughing!
start laughing from the strating point till the finishing line! they said is 50m?
LOL!!!!!!
I think we are the slowest pair!
HAHAHA!!!!
and the most funniest pair!
none of the pair laughed throughout one la!
LOL!!!!! but it's fun, it's fun!!!
like SERIOUSLY FUN! =)

nt bad la... after the whole race, there's red bull to drink!
hahaax!!!
got alot alot og goodies also!
sounds so cheapo right?!!!!!!
WHAT'S INSIDE THE BAD?!!
TATA>>
i nv try this b4 la!!! it's delectable!

woot`!!!
somemore i like bitter chocolate!
heehs!

TEENS magazine (March 2009 issue).
knw why i got 2?
LOL!!
at 1st i wasnt participating, so i korp the magazine from Freddy's goody bag.
LOL!!!
lately, i went to challenge it as well!
HAHAHA!!!

know wat's this?
LOLS!!!
it's a notebook. cute right?!!!!
hahahaha!!

Just a intro of wat wheelbarrow is about?

and more other bags inside the blue bag!
HAHAHAH!!!

a HP strip. unique eh..

I think ppl will start to have back, muscles aching after the challenge..
, so they provided the above products!
HAHAA!!!

There's actually one clothes in each bag!!! -_-

PEOPLE must replenish their enegry after the challenge!
lols.

I think it's electrolytes to give us ENERGY!lol.s

SALT!!! for wat?lols..
we need NaCl in our body to carry out more functions!

LASTLY!, was presented a CERT for participating the Wheelbarrow challenge!
hehes!
There's other events! but i dnt have any pic of those.
sont able to shar with u ppl la...
wat a pity =(
Endurance challange was woot~!!!
the longest is 1hr 10min i think?
tat's very long u knw!!!!

in THIS POSITION!!!!
can u do it?
and to my surprise, it's nt dragonboater who did it. it's ROCK-CLIMBER!
lols..
WELL DONE, Climber!







 Vinrio parahaemolyticus
Vinrio parahaemolyticus

Aspergillus niger
Aspergillus niger Salmonella enteritidis
Salmonella enteritidis



















 They very cute right.Lol!
They very cute right.Lol!






















